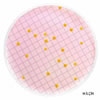

| Chapman Agar |
|---|

Chapman Agar |
| G�da ve di�er materyalde Staphylococcus t�rlerinin aranmas� / say�lmas� i�in kullan�lan besiyeridir. |
| Chapman Agar |
|---|
Chapman Agar |
| G�da ve di�er materyalde Staphylococcus t�rlerinin aranmas� / say�lmas� i�in kullan�lan besiyeridir. |